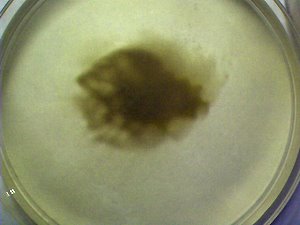

MORGELLONS : IN
THE LABORATORY
Clifford E Carnicom
May 22 2011
[Note - Notice the role of iron, which has been found in toxic levels in water, soil, and air samples, thought to be the result of aerosol spraying -- MC]
Note: I am not offering any medical advice or diagnosis with the presentation of this information. I am acting solely as an independent researcher providing the results of extended observation and analysis of unusual biological conditions that are evident. Each individual must work with their own health professional to establish any appropriate course of action and any health related comments in this paper are solely for informational purposes and they are from my own perspective.
This paper summarizes the status of current projects within a laboratory setting with respect to the "Morgellons" condition. The paper will by necessity be brief; if additional time becomes available the subjects will be elaborated upon. Each of these are worthy of their own discussion, but for the time being the following topics will be briefly discussed:
1. The role that iron appears to play in the growth of the underlying organism.
2. The expected impact of the organism upon the blood.
3. A set of minimum conditions that allow the growth of the organism.
4. A variety of growth forms have been identified; they possess, however, a common spectral signature.
5. The apparent unique spectral signature of the underlying organism.
6. Additional frequency analysis and the apparent impact upon the growth of the organism; considerations across the electromagnetic spectrum.
7. A spectral method to outline the potential presence of the organism within the blood of an individual and the expected impact upon the blood.
8. Indications of increased acidity in correlation with the "Morgellons" condition. The role of pH in the corrosion rate of iron. The diminished capacity of red blood cells to absorb oxygen in a more acidic environment.
9. The success of growth of the organism in a blood based culture medium.
10. Additional strategies, beyond alkalization and anti-oxidation, to be considered in the mitigation of the growth of the organism.
These subjects will now be discussed in greater detail:
1. The role that iron appears to play in the growth of the underlying organism:

See: Titantic, Resting or Reacting1
and
A
Mechanism of Blood Damage2
A primary focus of this researcher remains upon the sub-micron bacteria-archaea-like organism that appears to underlie the existence of the so-called "Morgellons" condition. This particular organism is the smallest identifiable feature and growth form of essentially all of the studies on this site related to the Morgellons condition over the years. This remains the case in both the environmental samples that have been analyzed as well as the extensive observations of human blood and filament samples. There is no reason known at this time to depart from this course of action as it remains as the primary source of impact upon the body that has been identified thus far. It is acknowledged that other forms or variations may well exist, but until sufficient documentation of such variations is presented I will continue to seek the lowest common denominator within the studies that are in place. My focus of study remains on the influence of the organism internal to the body vs. external manifestations.
There appears to be little doubt now that the organism can and does feed upon iron. This conclusion is reached by both direct observation and by inference. With respect to direct observation, numerous cultures have now been developed based upon both the use of the bacteria-archaea-like organism as well as the from the human oral filament samples. Several variations in the culture mediums have been tried, including agar (beef and blood), wines (red and white), simulated wines, restricted solutions of iron sulfate and hydrogen peroxide, and more recently, dilute human blood. They are all productive to varying degrees.
With respect to iron consumption, rapid growth can now be observed and recorded with the use of water, iron sulfate and hydrogen peroxide alone. This observation refers back to earlier work, such as that presented in the paper entitled, Morgellons: A Discovery and A Proposal3. This relationship with iron has been confirmed only more strongly over time. It can now also be posited that an iron oxide form is created within the organism during the metabolic process as the tell-tale color of rust within the organism is assumed within this restricted growth environment. It is a known fact that many of the archaea species can feed on iron and sufur in an extremely hostile environment; contemporary research is very active in that regard. The observations of survival of the organism under the harshest of conditions is one of the very reasons for the development of the paper entitled, Morgellons : A New Classification4. If is also of interest that genetic research is underway to inhibit the ability of such organisms to consume iron as well as to understand the growth and metabolic processes involved,5,6. Such research is immediately relevant to the interests of the Carnicom Institute, but sufficient resources to engage at this level of study are not available at this time. In addition, by inference from the extended observation of blood, the use of iron in the growth process of the organism is sustained as a conclusion; this topic will be discussed further in the next section of this report.
2. The expected impact of the organism upon the blood:
|
|
|
An observed method of blood damage has previously been reported on (A Mechanism of Blood Damage). The agent responsible for the damage being spoken of is the bacteria-archae-like organism that is at the center of this research. The progression of damage first includes the introduction of the organism into the serum of the blood. The second stage involves the attaching of the organism to the outside walls of the erythrocytes, or the red blood cells. The next stage involves the breaching of the erythrocyte cell walls. The latter stages result in essentially an invasion into the cell and a breakdown in the general integrity of the cell. In some cases this damage is extreme and the blood itself is no longer even recognizable from a conventional viewpoint.
When we combine damage to the integrity of the erythrocytes at the level recorded along with a demonstrated ability to consume iron, it is not any extension of logic to presume that metabolic imbalances of iron content in the human body are likely to occur from this damage. This is in addition to the diminished capacity of the blood to perform the essential functions of oxygen, nutrient transport and waste removal. Each individual must pursue their own evaluation of this issue with the medical professional of their choice; my only purpose here is to present the information which must be considered from a logical point of view in conjunction with direct observation.
Iron is a core element in the formation of hemoglobin7. An iron consuming organism, in direct conjunction with the manifestation of the Morgellons condition, has been identified. It is to be expected that damage to the blood and that interference with iron metabolism will occur in conjunction with the extensive presence of this organism within the blood. Again, each individual must consult with their own health professional on any consideration given to this information.
3. A set of minimum conditions that allow the growth of the organism:
Over the past few years, various culture mediums have been used to develop the filament colonies, with emphasis upon the use of oral samples. There remains additional work to be done, as a good portion of the success or failure has been through trial and error in addition to conjecture. The early cultures were developed in an agar medium, with both blood and beef broth as a base. These cultures were successful and introduced some of the more exotic findings involving erythrocytic forms within the growth stages. Numerous papers have been issued on that aspect of the Morgellons issue as well, (e.g., Artificial Blood?8, Blood Issues Intensify9, Morgellons : A Status Report10.)
The next stage of culture development involved the accidental discovery of success using red wine, the very same solution that is commonly used to extract the oral samples. This finding was a complete accident, and resulted from leaving oral extractions undisturbed for several weeks to even months within that solution.
The next discovery was that white wines were also successful for growth of the culture (not so for extraction, however, as there is a dye process attached with the use of red wine). The white wines have the distinct advantage of allowing observation in a translucent medium, which makes the monitoring of growth under a low power scope much easier. They white wines may or may not be as favorable to growth, however, this remains unclear. Simulated wine mediums were also developed to replicate the general chemistry of wine, however, no particular advantage of that effort came about. The chemistry of wines is in general, quite complex, and increases the difficulty of analyzing the metabolic requirements for growth using that medium.
The most recent culture work produces a somewhat surprising result, and this is that the medium of growth can actually be relatively simple. In earlier work(ibid., Morgellons: A Discovery and A Proposal), it has been found that the addition of iron sulfate and hydrogen peroxide enhances growth within the wine medium. This process was described in detail and the issues of alkalinity vs acidity and anti-oxidants vs oxidants were raised on in a serious tone. The importance of those findings remains as influential as ever upon the prospects for mitigation of the "condition".
It has now been discovered that prolific growth can occur in a medium of only water, iron sulfate and hydrogen peroxide. It is now feasible that growth will occur in even a more restricted medium. It is known, however, that sufficient growth for analysis can easily be established within this simplified medium. This has both advantageous and disadvantageous implications in the research. As an advantage, it simplifies the requirements of analysis. As a disadvantage, particularly as it relates to the importance of iron within human metabolism, it prevents some formidable obstacles to proposals that seek to inhibit or eliminate the growth within the body. Please recall the earlier reference made to the active genetic research seeking the inhibition of iron consumption within certain bacterial or archaeal forms. Unfortunately, the Institute does not have access to such resources at this time; hopefully there are those that desire to support such needs and causes.
In addition, the organism has been subjected to numerous exposures from caustic agents, acids, extremes in temperature and the lack of moisture; these have produced no detriment to its existence. These latter additions only complicate the issue further and raise the bar for recognition of the resources required to approach the problems in earnest.
4. A variety of growth forms have been identified; they possess, however, a common spectral signature.

There are several variants of growth forms that have been identified in the culturing process, but at the microscopic level they appear that they are essentially the same form. Some of these variations include:
1. An original oral or skin filament growth form.
2. The early stages of culture growth, which are somewhat amorphous in structure.
3. The emergence of the primary filament structure on the surface of the medium.
4. The emergence of more substantial filaments, usually colored, at the bottom of the liquid culture medium
5. The more substantial filament form representative of a maturing culture. The first stage of this growth is pure white in color.
6. Successive stages in the colors of the maturing filament growth, progressing through green and eventually black colors.
7. A newer and unusual form of growth that has recently been reported when subject to blue light energy. Although still filamentous in nature to the visible eye, this is of a much coaser nature that demonstrates an explosive growth cycle.There is reason to believe that many more "exotic" forms of growth are associated with the Morgellonscondition but these will require more detailed documentation and examination to include them within the current scope of study.
An important observation is that, regardless of the variation in surface morphology, color or structure, the underlying spectral signature of the organism appears to be the same.
5. The measured spectral signature of the underlying organism.

The measured spectral analysis of the culture form in the visible light and near-infrared portion of the spectrum.
A modern and professional spectrophotometer of high resolution has been acquired by the Carnicom Institute. Many thanks are extended to the the donors that have made this possible; additional laboratory equipment and a facility to operate from remain in need. The availability of this equipment has advanced the rate of progress by a factor of months with respect to certain problems to be solved. The instrument has also made numerous accomplishments possible which have not been accessible or available until this equipment came on board.
Essentially a unique signature of the organism has been identified; this has numerous advantages in objectively identifying the existence and presence of the organism. Please notice the similarity of this spectrum to that laboriously obtained with vintage equipment, as described in the paper, The Biggest Crime of All Time11. Further discussion on the importance and application of this work will be discussed in time.
6. Additional frequency analysis and the apparent impact upon the growth of the organism; considerations across the electromagnetic spectrum.
A process of remarkable growth has recently been described within the paper, A New Form: Frequency Induced Disease?12 The project illustrated below is an extension of that finding and it sets the stage for further work in the future. The spectrum obtained shows that energy absorption by the organism reaches a maximum of approximately 390 nanometers in the visible light range. This characteristic appears to be a factor in the paper referenced immediately above. One question that arises from this work is whether or not harmonic frequencies corresponding to this wavelength may also be involved in affecting the growth of the organism. It may be beneficial, for example, to consider the ideas expressed within the paper entitled "A Look at the Frequencies of Rife-related Plasma Emission Devices" by Charlene Boehm13.
The general ideas expressed within that paper have been applied in the section that is being briefly described here. One reason to consider harmonic frequencies is that frequencies outside of the visible light range can have either greater or lesser ability to penetrate the skin or internal organs of the human body. The discoveries and controversies of Royal Raymond Rife in this arena are well known by many. Another consideration of such frequencies is their ability to either enhance or inhibit, or even destroy, certain organisms or pathogens. The risks and uncertainties of engaging blindly or in a foolhardy fashion using these methods have been already been clearly stated and will not be repeated here.
.
See: A New
Form: Frequency Induced Disease?
The harmonic frequencies to consider can be arrived at by multiplication or division by increasing powers of two. The speed of the electromagnetic wave within the medium involved (vacuum, air, liquid, human tissue, etc.) must certainly be a part of the analysis. The case below shows the application of an electromagnetic wave at approximately 500Hz to a culture medium. The method of deducing that approximate frequency for application can be discussed at a later time. The current through the medium was measured at approximately one millliwatt.
What is clearly demonstrated below is an increased growth rate in the culture, especially in the electrode regions. An advancement to the filament stage of growth is clearly evident as a result of the current and/or frequency combination. The sensitivity of the process to a change in frequency is simply not known at this time; it is possible that the results may not be as much frequency dependent as they are current induced. Extensive research on this topic remains a prospect; a multitude of harmonic frequencies and or current combinations may be tested if the equipment becomes available.

7. A spectral method to outline the potential presence of the organism within the blood of an individual and the expected impact upon the blood.
The graphs shown below are of much importance and they will be instrumental to numerous applications in the future. It is now known that the metabolic process of the organism has a strong dependence on iron. It is also known that the organism causes serious degradation to the condition of the blood, and the consumption of iron within the blood is most certainly an obvious important factor within the research.
A thesis is proposed that the influence and impact of the organism upon the blood can be established through the use of spectral analysis. An example of such influence and impact is shown below. Nothing presented here is to be interpreted as a diagnostic procedure of any kind, and the disclaimer above is repeated here for emphasis:
|
Note: I am not offering any medical advice or diagnosis with the presentation of this information. I am acting solely as an independent researcher providing the results of extended observation and analysis of unusual biological conditions that are evident. Each individual must work with their own health professional to establish any appropriate course of action and any health related comments in this paper are solely for informational purposes and they are from my own perspective. |
The approach that is presented here is offered freely to the medical community at large for their consideration in future strategies developed for the mitigation, reduction or elimination of this condition. While not diagnostic in nature, the detection of the organism within the blood and the impact upon the blood does appear evident as a result of this research. It will be for the medical community to determine the viability of the method in specific applications. The purpose here is to summarize the methods and findings; futher discussion in detail will again need to be reserved for the future.
, t
This graph shows an overlay between the expected spectrum of hemoglobin (reference spectrum in black) and the spectrum of an individual that shows the presence of the organism under research within the blood. This organism is the same as that which is subsequently developed into a culture (predominantly filamental) form.
The organism alters the hemoglobin in a very distinctive fashion that is identifiable and repeatable. Most noticeably, the presence of an anomalous, or unexpected sharp peak in the spectrum occurs at approximately 390 nm. This peak that appears in such prominent fashion within the affected blood is not expected to be a part of the normal hemoglobin spectrum. This influence, amongst others, presents itself as an important and viable method for the detection of the organism within the blood of an individual. There are additional measurable influences upon the spectrum, such as the sharper decline in absorbance in the 430-500 nm range, as well as the diminished absorbance in the 700-900 nm range. Another consequence of the combination of influences in the spectrum is a shifting of the primary peak in hemoglobin at 414 nm to approximately 425-430 nm. These changes in the spectrum are anomalous, measurable and repeatable; they will be of much value in future research related to the "Morgellons" condition.
|
|
|
The theoretical reference spectrum for hemoglobin14. Peaks occur at 414, 542 and 576 nm respectively. |
|
|
|
The measured spectrum of the organism in culture form. This spectrum is identical to that of the environmental and human biological samples that have been discussed in detail on this site. |
|
|
|
A representative measured spectrum of hemoglobin that is affected by the presence of the sub-micron organism under study. Modification of the reference specrum has been discussed above. |
|
|
|
|
A mathematical model developed to demonstrate how the reference hemoglobin and the organism spectra combine to create the affected hemoglobin spectrum. It is proposed that this model form will be useful in estimating the degree of influence of the organism upon the hemoglobin. |
The mathematical model of the affected hemoglobin segregrated from the combined model chart to the left. This model can be used as a framework for comparison to the measured spectrum of an affected hemoglobin sample shown immediately above. It is determined that the composite spectrum results essentially from the weighted combination of exponentially scaled terms of the original component spectra. The weights assigned to the individual terms are likely to be an expression of the influence of each component relative to the whole. |
The graphs shown above
essentially present the components that combine to produce the altered
hemoglobin spectrum discussed above. The spectra shown here will be
the basis of much study and examination in the future. It has been
stated on many occasions that the condition of the blood and the presence
of filaments within the body appear to this researcher to be a more
accurate method of assessing the presence of the condition. The use
of spectral analyses may allow for a greater level of objectivity in
this approach.
8. Indications of increased acidity in correlation with the "Morgellons" condition. The role of pH in the corrosion rate of iron. The diminished capacity of red blood cells to absorb oxygen in a more acidic environment.
It is known that the organism thrives within an acidic environment. There is also reason to consider that the organism itself may increase the acidity of the human biological state. It is also a fact that iron (blood contains iron) corrodes more quickly in an acidic environment. Lastly, in an increased state of acidity within the human body and blood cells have a diminished capacity to absorb oxygen. These factors are in addition to the structural damage of the blood by the organism as it has been repeatedly described.
9. The success of growth of the organism in a blood based culture medium.
It has been established that human blood is a productive medium for the growth of the organism in a cultured form. In the case below, the stock culture solution is prepared using sodium hydroxide (lye) and heat to break down the filaments as has been repeatedly described. Iron sulfate and peroxide was used to begin the culture process. Human blood was then introduced into the culture medium to test further growth. The growth rapidly escalated and immediately established itself in the mature filament form. The rust color of iron-oxide is again visible. All testing in all ways to date strongly supports the contention that iron is a primary source of nourishment to the organism.
.jpg)
A filament culture developed from human blood as the primary source of nourishment to the culture.
10. Additional strategies, beyond alkalization and anti-oxidation, to be considered in the mitigation of the growth of the organism.
The statements below may also be of great importance during future research and analysis. It has already been reported that alkalization of the body and the use of antioxidants may serve a role in the mitigation of the growth of the organism. This has been described in depth within the papers entitled Morgellons: A Discovery and A Proposal and Growth Inhibition Confirmed16. Again, no medical advice, diagnosis or therapy of any kind is being provided and all discussions relate to that of observation and analysis only; each individual must consult with their own medical practitioner for health related advice.
The role of the consumption of iron that is now understood more deeply as well as the visible damage to the blood leads us to consider additional strategies that may be of a more proactive nature in the mitigation of growth of the organism. We are now able to ask additional questions in a more forthright fashion, and seek those answers:
1. What is it that will allow for greater absorption of iron by the body? Conversely, what compounds may act to inhibit the absorption of iron by the body?
2. What is it that might inhibit iron-eating bacterial-archael forms (or modifications thereof) in a manner that will allow existing iron to be more fully utilized in the body?
These questions are the genesis for potentially fruitful discussions in the future, in addition to those of alkalinity and anti-oxidation that have been established. We may, at this point, at least begin the discussion.
One answer to the first question involves Vitamin C. Vitamin C increases absorption of iron in the body17. Vitamin C is also essential in the production of hemoglobin18. It is also of interest that Vitamin C is also an antioxidant, and plays an important role in paper most recently referenced. But in addition to being an anti-oxidant, Vitamin C also can improve the absorption of iron by the body. There are now two important reasons that Vitamin C may be considered in the development of strategies to inhibit or mitigate the growth of the organism. Facilitators for iron absorption are stated to include ascorbate, citrate and amino acids. Inhibitors in iron absorption are stated to be phytates, tannins, soil clay and antacids for example19.
Lastly, let us introduce an initial response to the second question; this consideration also leads us to many interesting avenues of discussion for the future. There is indeed a certain protein, commonly found in mother's milk, than inhibits the growth of iron-dependent bacteria in the gastrointestinal tract20. The name of the protein is lactoferrin. Although this paper is not to be a discussion on the topic of breastfeeding, the constituents of human milk become immediately relevant to the research at hand. The anti-bacterial properties of human milk, (i.e., especially with respect to the iron situation) are extremely important for our consideration here. The mechanism involved in the defense is the binding of the iron with the lactoferrin protein21, and this prevents the more direct consumption by the iron-eating bacteria (or potential modification thereof). This is the principle of a chelate.
The obvious manner in which to end this discussion for now is to ask whether there are any commonly sources of lactoferrin available to humans beyond the infant stage. The research at this time indicates at least one available source - whey21,22. Concentration levels in various sources as well as their efficacy will be major points of consideration in the future. Culture trials will eventually measure the impact of this protein and compound upon growth rates, in combination with the additional strategies that have been outlined previously. Initial results are encouraging. A recent comment sent independently to the Institute by a medical professional supports the prospective benefits outlined with respect to lactoferrin, and this suggestion is appreciated.
In summary, four strategies have evolved that may demonstrate or show some degree of effectiveness in the mitigation or reduction in the growth of the organism.
They are: alkalization, anti-oxidation, increasing the utilization and absorption of existing iron, and the inhibition of the growth of iron-consuming bacteria (and bacterial-archeal like) forms. Each of these strategies have developed through direct research, observation, study and analysis within a laboratory environment. They are each offered to the medical and health community for consideration and evaluation as they apply to the human condition.
This particular paper represents only a summary view of the topics that are deemed worthy of pursuit by this researcher and the Carnicom Institute. Additional discussion or presentation will occur as time and circumstance permit. If you wish to contribute more directly to the research and/or contribute resources to this cause, please contact the Carnicom Institute (http://www.carnicominstitute.org/).
Sincerely,
Clifford E Carnicom
(born Clifford Bruce
Stewart Jan 19 1953)
References:
1. Titanic-Resting-or-Reacting, Sarah Don, 2008.
2. A
Mechanism of Blood Damage, Clifford E
Carnicom, Dec 2009.
3. Morgellons: A Discovery and a Proposal, Carnicom, Feb 2010.
4. Morgellons: A New Classification, Carnicom, Feb 2010.
5. Metal-Eating Bacteria Corrode Pipes in Oil
Industry, Access Excellence,
2004.
6. Iron
Eating Bacteria Deciphered,
Gauntlet, 2004.
7. Blood Diseases : Anemia,
University of Maryland Medical Center, 2011.
8. Artificial Blood?, Carnicom, Aug
2009.
9. Blood
Issues Intensify, Carnicom, Apr
2009.
10.Morgellons: A Status Report, Carnicom, Oct 2009.
11.The
Biggest Crime of All Time, Carnicom,
Mar 2011.
12. A New
Form: Frequency Induced Disease?,
Carnicom, Mar 2011.
13.
A Look at the Frequencies of Rife-related Plasma Emission
Devices by Charlene Boehm,
1999.
14. Optical Absorption of Hemoglobin, Scott Prahl, Oregon Medical Laser Center.
15. Ultraviolet
and Visible Spectroscopy, 2nd Edition, Michael Thomas, John Wiley &
Sons, 1996, p. 20.
16. Growth Inhibition Confirmed,
Carnicom, Mar 2010.
17. How to Increase Iron Absorption, Kristie Leong, MD.
18. Iron Deficiency Anemia, National Insitutes of Health.
19. Iron Absorption,
Harvard University.
20.What's in Breast Milk? American Pregnancy Association.
21. The Truth About Iron While Breastfeeding, Gwen Morrison.
22. Protein Powders, Abstract (informational only-no product support).
Source: http://www.carnicom.com/bio2011-4.htm